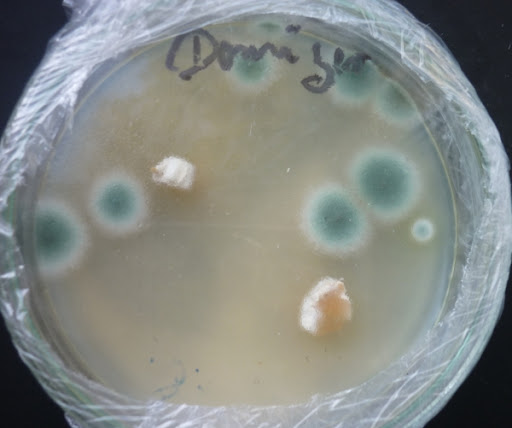

mit den Beiden und nen Kumpel von Reblaus war ich letztens mal in de Schwamme, wie wir hier sagen.
Leider haben wir nicht so viel gefunden.
2 Tage später hab ich dann das gefunden.
Das sind 11 Parasolpilze. 4 sind total offen, 3 gewölbt und 4 sind noch total zu.
Die 4 Offenen hab ich paniert. Feine Sache.
Desweiteren haben wir auch noch ne Krause Glucke in der Nähe gefunden. Gibt also doch Pilze in Brandenburg.
Heute bin ich wieder da und was gabs gleich hier zu finden, einen kleinen knuffigen Steinpilz. Werd morgen mal gehen. Hoffe auf Pfifferlinge uvm.
Schwamme frei